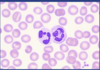
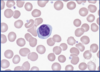
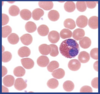
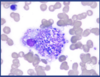

Glands have ________ and _______ layers
Stomal and epithelial
Define hypertrophy
Increase in cell size
Define anaplastic
Poorly differentiated malignancy → does not resemble original cell type
Define hyperplasia
Increase in cell number
Cardiac hypertrophy can be seen physiologically in pregnancy due to……
Increase in blood volume
Define dysplasia
Pre-malignant change in which cellular DNA has begun to accumulate but has not developed the ability to invade
Define Metaplasia
A reversible change from one mature cell type to another mature cell type in response to a stimulus
Outline metaplasia in Barret’s oesophagus
Squamous epithelium to intestinal type columnar epithelium (mucin rich goblet cells) indicating intestinal metaplasia
Outline metaplasia that can occur in lungs of smokers, etc
Columnar epithelial cells to squamous epithelial cells
Greatest source of oestrogen comes from…
Adipose tissue
Lynch syndrome is also known as…
Hereditary non-polyposis colorectal carcinoma
Lynch syndrome is a….
Autosomal dominant mutation in DNA mismatch repair genes (micro satellite instability)
Lynch syndrome increases risk of which cancers?
Colorectal, Endometrial, Transitional cell carcinoma (TCC) (bladder and ureteric cancers)
________ is used to look for expression in tumour, MSI and mutation in Lynch syndrome
Immunohistochemistry
Which encoded proteins are related to Lynch syndrome?
MLH1, MLH3, MSH2, PMS1 and PMS2
Define Neoplasms
A new and abnormal growth of tissue in a part of the body
T or F: Leiomyomas are neoplastic
True
Leiomyomas arise from ___________ cells
Smooth muscle
As a connective tissue tumour, Leiomyosarcomas consist of _________
spindle cells
Leiomyomas tend to arise between ________ and ________ as they are ________ dependent
Menarche
Menopause
Oestrogen
T or F: Leiomyosarcoma (malignant) are really common
False
CGIN is a……
High grade glandular abnormality
CIN is…..
Squamous abnormality
Features of PAP smear consistent with HPV infection
Irregular nuclei with binucleate forms and a strange perinuclear halo